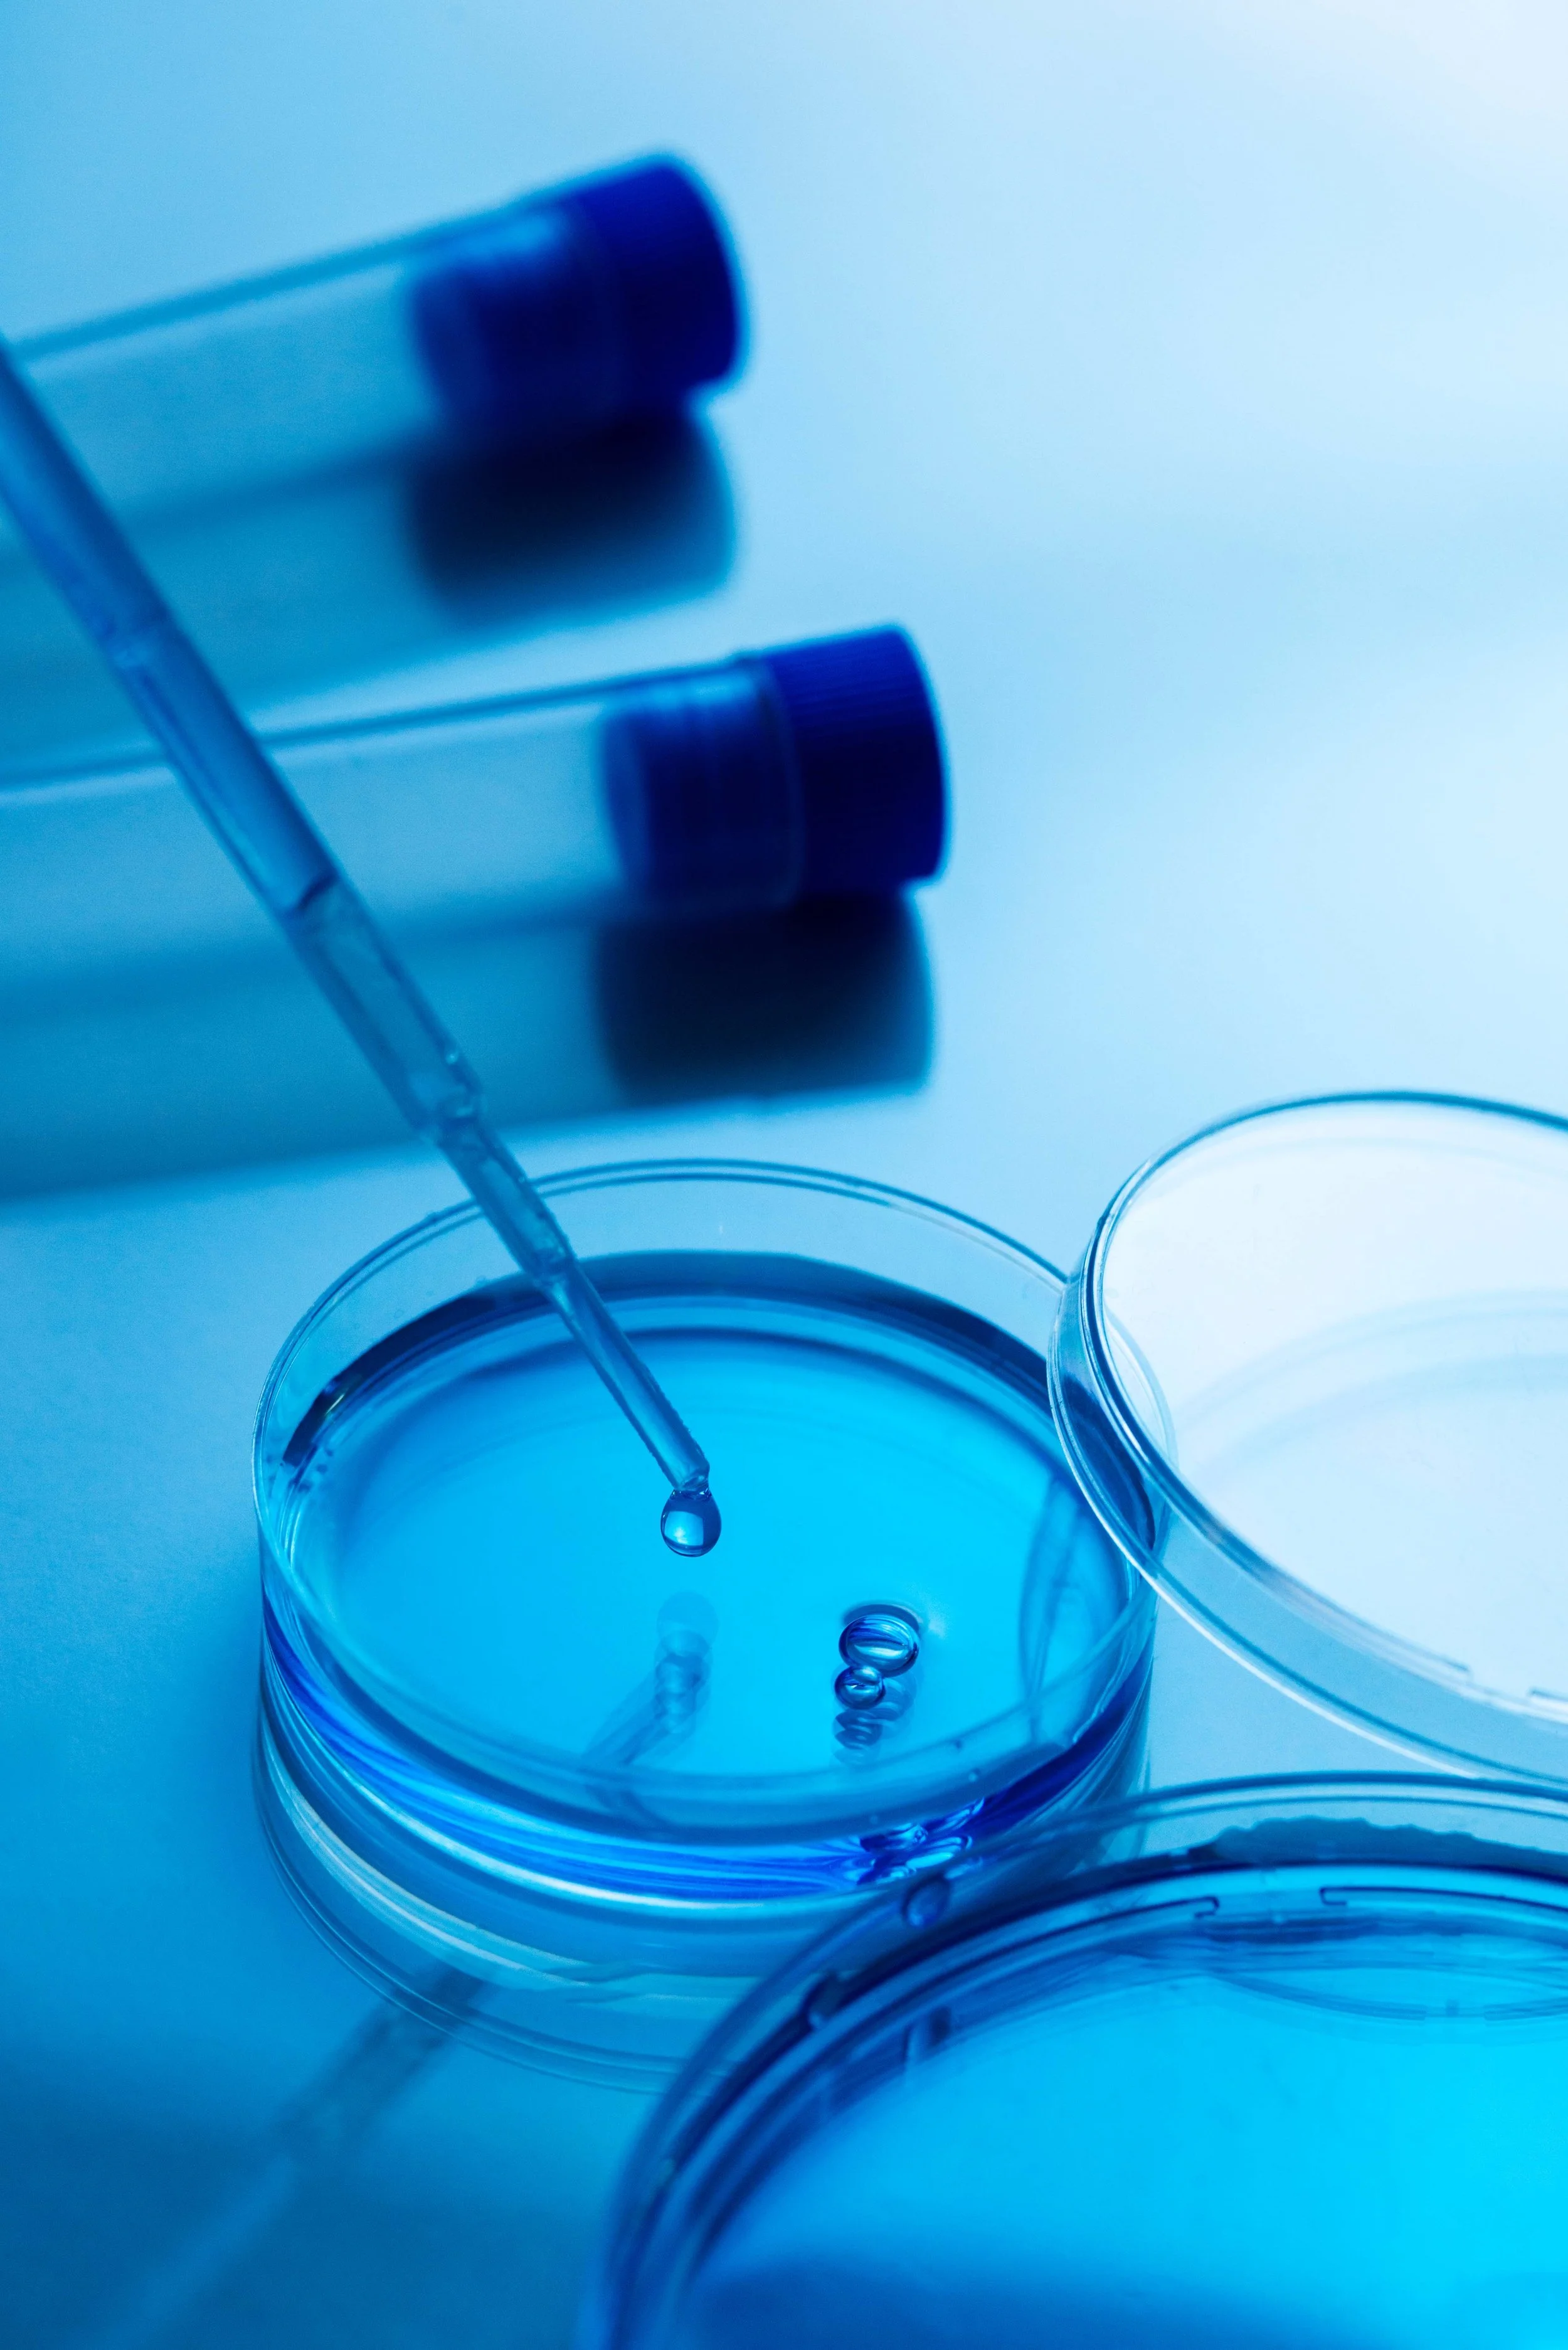

It starts from the basics: revolutionize fertility care with us
Our Approach
Labryo Reproductive Services offers cutting-edge fertility care through the knowledge and skill of top reproductive specialists and embryologists. Our IVF facility, together with partner physician practices, collaborate to advance the quality of fertility treatment, providing modern, research-driven services that give hopeful parents the greatest chance of a successful pregnancy.
Physicians work alongside Labryo Reproductive Services to provide patients with innovative and groundbreaking IVF options. Our best practices are your best practices.

